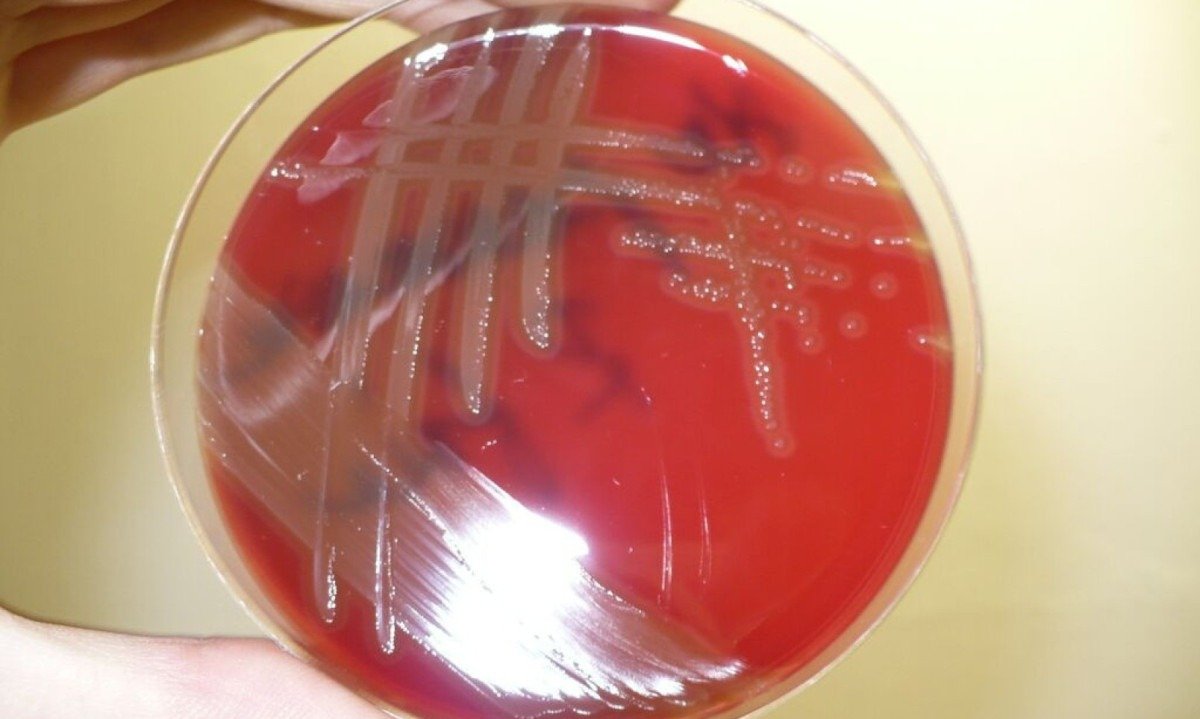

Pneumonia e meningite: estudo analisa a resistência da bactéria causadora
Resultados podem contribuir para o desenvolvimento de novos tratamentos contra o pneumococo, responsável por cerca de um milhão de mortes anuais no mundo
compartilhe
Siga no
Por Ricardo Muniz
Estudo publicado na Scientific Reports analisa o papel da proteína de superfície A (PspA), molécula produzida pelo pneumococo Streptococcus pneumoniae, bactéria responsável pela pneumonia, que o protege dos mecanismos de defesa do hospedeiro. A investigação focou especificamente na interação da bactéria com a indolicidina, um peptídeo antimicrobiano (AMP, na sigla em inglês) de origem bovina que apresenta amplo potencial.
Os AMPs,também chamados de peptídeos de defesa do hospedeiro, são capazes de matar diversos tipos de patógenos, incluindo vírus, bactérias e fungos.
- Novo imunizante contra bronquiolite e pneumonia chega ao Brasil
- Meningite: atualização no esquema vacinal amplia proteção contra a doença
“O aumento da resistência a antibióticos tem dificultado o tratamento das infecções causadas por pneumococo, fomentando a busca por novas terapias”, contextualiza Michelle Darrieux Sampaio Bertoncini, doutora em biotecnologia pela Universidade de São Paulo (USP) com pós-doutorado pela Universidade de Lund, na Suécia. “Nossos resultados indicam que pneumococos mutantes que não produzem PspA são mais sensíveis à morte por indolicidina e também que a remoção química da proteína da superfície da bactéria favorece a ação do antimicrobiano”, resume.
O grupo de pesquisadores verificou que, na direção contrária, a adição de PspA fortalece a bactéria no embate com o AMP, permitindo supor que a proteína interage diretamente com a indolicidina – a ligação entre as moléculas, inclusive, foi confirmada por espectrometria de massas. Por fim, a adição de anticorpos produzidos contra a proteína PspA aumenta a morte da bactéria pelo AMP.
Leia Mais
“Em conjunto, os resultados indicam que a proteína PspA está envolvida na proteção da bactéria contra a ação da indolicidina e que essa proteção envolve o sequestro do AMP pela PspA, impedindo que atravesse a membrana bacteriana e cause sua morte”, diz a pesquisadora, que é docente do programa de pós-graduação em ciências da saúde da Universidade São Francisco, em Bragança Paulista, onde desenvolve projetos na área de desenvolvimento de novas formulações vacinais contra patógenos humanos e análise da interação patógeno-hospedeiro.
- Pesquisadores criam prótese com antibiótico para tratar infecções
- Anvisa alega sigilo e omite número de infecções hospitalares por unidade de saúde
Em sua avaliação, os achados da investigação, apoiada pela FAPESP, poderão contribuir para o desenvolvimento de novos tratamentos ou vacinas contra o pneumococo, patógeno responsável por cerca de 1 milhão de mortes anuais no mundo, afetando principalmente crianças e idosos ao causar, além de pneumonia, várias outras doenças, como otite média, meningite bacteriana e sepse.
O artigo é assinado também por Natalha Tedeschi, Barbara Milani, Lucas Assoni, Thaís Parisotto, Lucio Ferraz e Thiago Converso (Laboratório de Microbiologia Molecular e Clínica, Universidade São Francisco); Guilherme Rabelo (Laboratório de Bioquímica e Biofísica do Instituto Butantan), Juliana Sciani (Laboratório de Produtos Naturais da USF) e Anders Hakansson (Division of Experimental Infection Medicine, Universidade de Lund, Suécia).
Siga nosso canal no WhatsApp e receba notícias relevantes para o seu dia
O artigo Pneumococcal surface protein A (PspA) prevents killing of Streptococcus pneumoniae by indolicidin pode ser lido em: www.nature.com/articles/s41598-024-73564-9.
